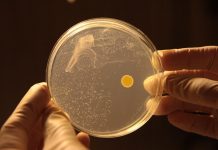
Australian Scientists Generate Electricity from Air Australian Scientists Generate Electricity from Air

Africa-Press – Rwanda. A global study on trust in Artificial Intelligence (AI) released recently reveals that more than half of the people globally are unwilling to trust AI, reflecting an underlying tension between its obvious benefits and perceived risks.
Key findings:
· The intelligent age has arrived – 66% of people use AI regularly, and 83% believe the use of AI will result in a wide range of benefits.
· Yet, trust remains a critical challenge: only 46% of people globally are willing to trust AI systems.
· There is a public mandate for national and international AI regulation, with 70% believing regulation is needed.
· Many rely on AI output without evaluating accuracy (66%) and are making mistakes in their work due to AI (56%).
Trust, Attitudes and Use of Artificial Intelligence: A Global Study 2025, led by Professor Nicole Gillespie, Chair of Trust at Melbourne Business School at the University of Melbourne and Dr Steve Lockey, Research Fellow at Melbourne Business School, in collaboration with KPMG, is the most comprehensive global study into the public’s trust, use and attitudes towards AI.
The study surveyed over 48,000 people across 47 countries between November 2024 and January 2025.
It found that although 66% of people are already intentionally using AI with some regularity, less than half of global respondents are willing to trust it (46%).
When compared to the last study of 17 countries conducted prior to the release of ChatGPT in 2022, it reveals that people have become less trusting and more worried about AI as adoption has increased.
“The public’s trust of AI technologies and their safe and secure use is central to sustained acceptance and adoption. Given the transformative effects of AI on society, work, education, and the economy, bringing the public voice into the conversation has never been more critical,” says Nicole Gillespie, Chair of Trust and Professor of Management, Melbourne Business School University of Melbourne.
AI at work
The age of working with AI is here, with three in five (58%) employees intentionally using AI, and a third (31%) using it weekly or daily.
This high use is delivering a range of benefits, with most employees reporting increased efficiency, access to information, and innovation. Almost half (48%) report AI has increased revenue-generating activity.
However, the use of AI at work is also creating complex risks for organisations. Almost half of employees admit to using AI in ways that contravene company policies, including uploading sensitive company information into free public AI tools like ChatGPT.
Many rely on AI output without evaluating accuracy (66%) and are making mistakes in their work due to AI (56%).
What makes these risks challenging to manage is that over half (57%) of employees say they hide their use of AI and present AI-generated work as their own.
This complacent use could be due to the governance of responsible AI trailing behind. Only 47% of employees say they have received AI training, and only 40% say their workplace has a policy or guidance on generative AI use.
It may also reflect a sense of pressure, with half concerned about being left behind if they do not use AI.
“The findings reveal that employees’ use of AI at work is delivering performance benefits but also opening up risk from complacent and non-transparent use. They highlight the importance of effective governance and training, and creating a culture of responsible, open, and accountable AI use,” says Gillespie.
AI in society
Four in five people report personally experiencing or observing the benefits of AI, including reduced time spent on mundane tasks, enhanced personalisation, reduced costs, and improved accessibility.
However, four in five are also concerned about risks, and two in five report experiencing negative impacts of AI. These range from a loss of human interaction and cybersecurity risks to the proliferation of misinformation and disinformation, inaccurate outcomes, and deskilling. 64% of people are concerned that elections are manipulated by AI-powered bots and AI-generated content. 70% believe AI regulation is required, yet only 43% believe existing laws and regulations are adequate.
There is a clear public demand for international law and regulation, and for industry to partner with government to mitigate these risks. 87% of respondents also want stronger laws to combat AI-generated misinformation and expect media and social media companies to implement stronger fact-checking processes.
“The research reveals a tension where people are experiencing benefits from AI adoption at work and in society, but also a range of negative impacts. This is fuelling a public mandate for stronger regulation and governance of AI, and a growing need for reassurance that AI systems are being used in a safe, secure, and responsible way,” Gillespie says.
KPMG International’s Global Head of AI, David Rowlands, said the report highlighted opportunities for organisations to lead the way in providing greater governance and taking a proactive approach to building trust with employees, customers, and regulators.
“It is without doubt the greatest technology innovation of a generation, and it is crucial that AI is grounded in trust, given the fast pace at which it continues to advance. Organisations have a clear role to play when it comes to ensuring that AI is both trustworthy and trusted. People want assurance over the AI systems they use, which means AI’s potential can only be fully realised if people trust the systems making decisions or assisting in them. This is why KPMG developed our Trusted AI approach, to make trust not only tangible but measurable for clients,” notes Rowlands, Global Head of Artificial Intelligence, KPMG International.
“The findings reaffirm what we’re witnessing across many African markets—an openness to innovation and a readiness to harness AI for real-world impact. Africa is not just adopting AI; it is embracing it with purpose. From Egypt, Nigeria, and South Africa, citizens and businesses alike are seeing AI as a lever for socio-economic progress, driving efficiency, accessibility, and innovation across sectors. This higher trust and adoption in emerging economies is a signal that the global AI narrative must be more inclusive, recognising that Africa is not on the side-lines, but is in fact helping to lead the way,” says Marshal Luusa, Partner, Technology & Innovation, KPMG in Africa.
Emerging economies lead the way
People in emerging economies report higher adoption of AI both at work and for personal purposes, are more trusting and accepting of AI, and feel more optimistic and excited about its use, compared to advanced economies.
They also self-report higher levels of AI literacy (64% vs 46%) and training (50% vs 32%), and importantly, more benefits from AI (82% vs. 65%), compared to people in advanced economies.
In emerging countries, three in five people trust AI systems, while in advanced countries, only two in five trust them.
“The higher adoption and trust of AI in emerging economies is likely due to the greater relative benefits and opportunities AI affords people in these countries and the increasingly important role these technologies play in economic development,” says Gillespie.
‘This report highlights a pivotal moment for Africa in the global AI journey. While trust in AI remains a global challenge, many African nations stand out for their optimism, growing adoption, and recognition of AI’s transformative potential, especially in bridging development gaps in healthcare, education, and financial inclusion. However, increased use must be matched with responsible governance, robust public-private partnerships, and regionally relevant AI literacy and regulation. In Africa, we have a unique opportunity to shape an AI future that is not only innovative but also inclusive and trustworthy,” concludes Luusa.
About this report
The University of Melbourne research team, led by Professor Nicole Gillespie and Dr Steve Lockey, independently designed and conducted the survey, data collection, analysis, and reporting of this research.
This study is the fourth in a research program examining public trust in AI. The first focused on Australians’ trust in AIopens in a new tab in 2020, the second expanded to study trust in five countries opens in a new tab in 2021, and the third surveyed people in 17 countries in 2022.
This research was supported by the Chair in Trust research partnership between the University of Melbourne and KPMG Australia, with funding from KPMG International, KPMG Australia, and the University of Melbourne.
About KPMG International
KPMG is a global organisation of independent professional services firms providing Audit, Tax, and Advisory services. KPMG is the brand under which the member firms of KPMG International Limited (“KPMG International”) operate and provide professional services. “KPMG” is used to refer to individual member firms within the KPMG organisation or to one or more member firms collectively.
KPMG firms operate in 143 countries and territories with more than 275,000 partners and employees working in member firms around the world. Each KPMG firm is a legally distinct and separate entity and describes itself as such. Each KPMG member firm is responsible for its own obligations and liabilities.
KPMG International Limited is a private English company limited by guarantee. KPMG International Limited and its related entities do not provide services to clients.
For more detail about our structure, please visit kpmg.com/governance
About KPMG in Africa
KPMG in Africa refers to the KPMG firms in the Southern, East, and West Africa regions. These are comprised of 13 countries from the 3 regional clusters, i.e. Southern Africa: Botswana, Mauritius, Mozambique, Namibia, South Africa, Zambia, and Zimbabwe; East Africa: Kenya, Rwanda, Tanzania, and Uganda; West Africa: Ghana, and Nigeria, who are in the process of establishing a formal One Africa Cluster to be called KPMG One Africa in 2025.
The KPMG firms in these countries are member firms of the KPMG global organisation of independent member firms affiliated with KPMG International Limited, a private English company limited by guarantee.
For More News And Analysis About Rwanda Follow Africa-Press